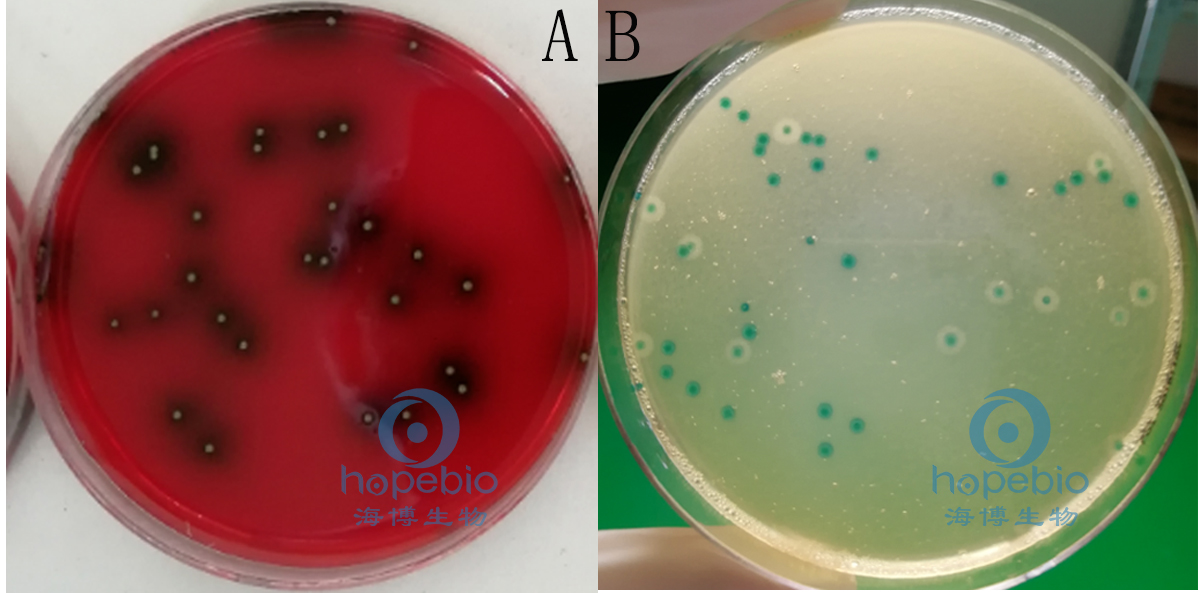

海博微信公众号
海博天猫旗舰店




一、简介
单核细胞增生李斯特氏菌(Listeria monocytogenes)简称单增李斯特氏菌,是一种人畜共患病的病原菌。它能引起人畜的李氏菌的病,感染后主要表现为败血症、脑膜炎和单核细胞增多。它广泛存在于自然界中,食品中存在的单增李氏菌对人类的安全具有危险,该菌在4℃的环境中仍可生长繁殖,是冷藏食品威胁人类健康的主要病原菌之一,因此,在食品卫生微生物检验中,必须加以重视。
二、参考标准
《GB 4789.30-2016 食品安全国家标准 食品微生物学检验 单核细胞增生李斯特氏菌检验》。
三、检验方法以及结果
单核细胞增生李斯特氏菌定性检验程序见图1。
图1 单核细胞增生李斯特氏菌定性检验程序
1.分离
将样品进行梯度稀释后,选择合适的稀释度涂布李斯特氏菌显色平板和PALCAM琼脂平板,于36℃±1℃培养24h~48h。
单增李斯特氏菌的典型菌落在PALCAM琼脂平板上为小的圆形灰绿色菌落,周围有棕黑色水解圈,有些菌落有黑色凹陷。在李斯特氏菌显色平板上为蓝色菌落,菌落周围有一不透明环。如图2所示:
A:PALCAM琼脂平板;B:李斯特氏菌显色平板
图2 单增李斯特氏菌在PALCAM琼脂平板和李斯特氏菌显色平板典型菌落特征
2.染色镜检
挑取纯培养的单个可疑菌落,进行革兰氏染色,单增李斯特氏菌为革兰氏阳性菌,镜检为紫色短杆状。如图3所示:
图3 单增李斯特氏菌革兰氏染色镜检结果
3.动力试验
挑取纯培养的单个可疑菌落穿刺SIM动力培养基,于25℃~30℃培养48h。单增李斯特氏菌有动力,在SIM培养基上方呈伞状生长。如图四所示:

图4 单增李斯特氏菌SIM动力试验结果
4.过氧化酶试验
挑取纯培养的单个可疑菌落,滴加3%过氧化氢酶试剂后,单增李斯特氏菌菌落在30s内产生大量气泡。如图5所示:
图5 单增李斯特氏菌过氧化氢酶试验结果
5.生化鉴定
选择过氧化氢酶阳性反应的菌落,继续使用海博单增李斯特氏菌的生化鉴定条进行生化鉴定,单增李斯特氏菌生化反应结果为木糖阴性、鼠李糖阳性、葡萄糖阳性、麦芽糖阳性、甘露醇阴性、七叶苷阳性、MR-VP阳性。如图6所示:
图6 单增李斯特氏菌生化鉴定条试验结果
注意事项:MR试验需在培养结束后滴加甲基红试剂1滴,立即观察结果,出现红色为阳性反应;VP试验需在培养结束后滴加VP试剂(甲液0.3mL,乙液0.1mL),混匀后观察结果(4小时内),出现红色为阳性反应。
6.溶血试验
将新鲜的羊血琼脂平板底面划分为20~25个小格,挑取纯培养的单个可疑菌落刺种到血平板上,每格刺种一个菌落,并刺种阳性对照菌(单增李斯特氏菌、伊氏李斯特氏菌)和阴性对照菌(英诺克李斯特氏菌),穿刺时尽量接近底部,但不要触到底面,同时避免琼脂破裂。36℃±1℃培养24h~48h,于明亮处观察。
单增李斯特氏菌呈现狭窄、清晰、明亮的溶血圈,英诺克李斯特氏菌无溶血圈,伊氏李斯特氏菌产生宽的、轮廓清晰的β-溶血区域。如图7所示:

A-1、A-2、A-3和A-4均为待测菌落;B:单增李斯特氏菌阳性对照;
C:伊氏李斯特氏菌;D:英诺克李斯特氏菌
图7 单增李斯特氏菌溶血试验结果
7.协同溶血试验
在羊血琼脂平板上平行划线接种金黄色葡萄球菌和马红球菌,挑取纯培养的单个可疑菌落垂直划线接种于平行线之间,垂直线两端不要触及平行线,距离1mm~2mm,同时接种单增李斯特氏菌、英诺克李斯特氏菌、伊氏李斯特氏菌,于36±1℃培养24h~48h。
单增李斯特氏菌在靠近金黄色葡萄球菌处出现约2mm的β-溶血增强区域,伊氏李斯特氏菌在靠近马红球菌处出现约5~10mm的“箭头状”β-溶血增强区域,英诺克李斯特氏菌不产生溶血现象。如图8所示:
A:金黄色葡萄球菌;B:马红球菌;C:单增李斯特氏菌阳性对照
D和G:待测菌;E:英诺克李斯特氏菌;F:伊氏李斯特氏菌
图8 单增李斯特氏菌协同溶血试验结果
三、结果判定
若待测菌在PALCAM琼脂平板上为小的圆形灰绿色菌落,周围有棕黑色水解圈,有些菌落有黑色凹陷;在李斯特氏菌显色平板上为蓝色菌落,菌落周围有一不透明环;镜检结果为革兰氏阳性杆菌;有动力、过氧化酶阳性、木糖阴性、鼠李糖阳性、葡萄糖阳性、麦芽糖阳性、甘露醇阴性、七叶苷阳性、MR-VP阳性,可初步判断为单增李斯特氏菌。
注:本文属海博生物原创,未经允许不得转载。
上一篇:粪大肠菌群计数标准解析
